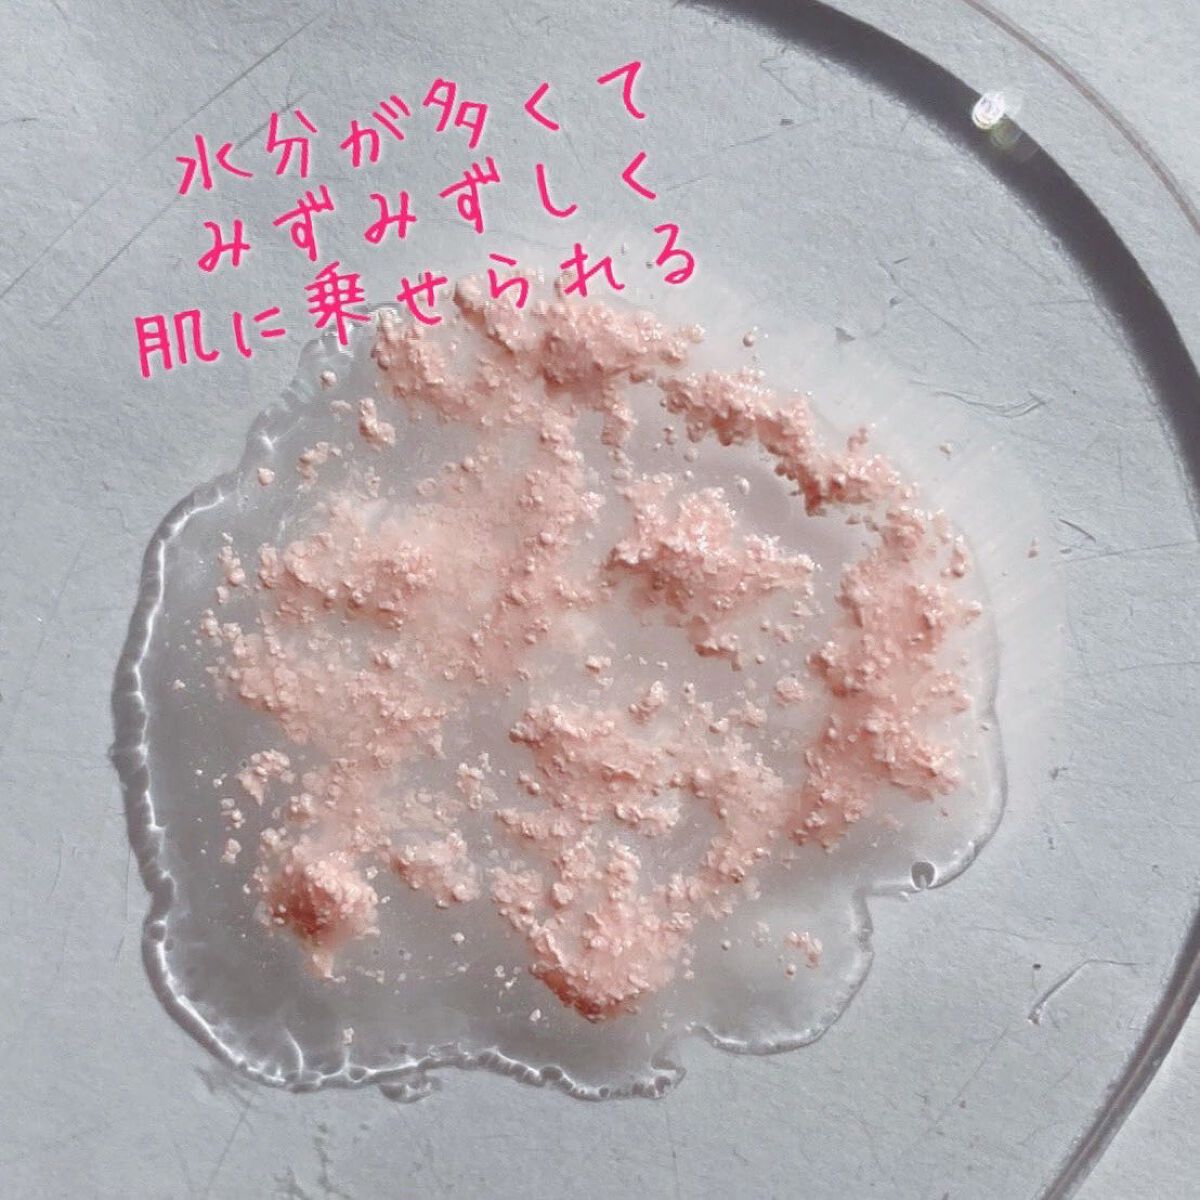
ビタミントーンアップサンセラム/VELY VELY/日焼け止めローションを使ったクチコミ(3枚目)

冬におすすめな保湿感抜群日焼け止め!VELYVELY毛穴ケアゆずCサンセラムビタミントーンアップサンセラムレビューVELYVELYの毛穴ケアゆずCサンセラムとビタミントーンアップサンセラムを購入しましたVELYVELYの毛穴ケアゆずCサンセラ...
もっと見るおすすめアイテムVELY VELY×日焼け止めローション
| 商品画像 | 商品情報 | 参考価格 | 評価 | ランキングIN | 特徴 | 商品リンク |
|---|---|---|---|---|---|---|
VELY VELY ビタミントーンアップサンセラム | 3,025円 |
| 日焼け止めローションランキング第73位 | グレープフルーツの香りとうるうるの美容液テクスチャで 朝のスキンケア感覚でつかえちゃう💘 | 詳細を見る | |
VELY VELY 毛穴ケアゆずCサンセラム | 3,025円 |
| 日焼け止めローションランキング第74位 | ゆずの香りもほんのり爽やかに香る。 | 詳細を見る | |
VELY VELY 肌ケアシカサンセラム | 3,025円 |
| 日焼け止めローションランキング第72位 | 伸ばせばつぶつぶ感もなくなって 少しひんやりしてくれます | 詳細を見る |
日焼け止めローションランキング
| 商品画像 | 商品情報 | 参考価格 | 評価 | ランキングIN | 特徴 | 商品リンク |
|---|---|---|---|---|---|---|
KANEBO ヴェイル オブ デイ | 5,500円 |
| 日焼け止め・UVケアランキング第9位 | みずみずしいジェル状クリームが気持ちいいです。 | 詳細を見る | |
excel プロテクティブ UVエッセンス | 1,540円 |
| 日焼け止め・UVケアランキング第11位 | とにかく軽〜い付け心地!するーっと伸びやすく、腕や足など広い範囲もスイスイ塗りやすい。 | 詳細を見る | |
スキンアクア スキンアクア ヒアルロンセラムUV | 1,320円 |
| 日焼け止め・UVケアランキング第7位 | 肌の上でスーッと伸びて、本当に美容液のようにサラサラ、塗っている感がすごくすくないのが感動! | 詳細を見る | |
ビオレ ビオレUV アクアリッチ ウォータリーエッセンス | 968円 |
| 日焼け止め・UVケアランキング第25位 | 潤い感がたっぷりでみずみずしい日焼け止めです🤍 軽い付け心地でさらっとぬれる | 詳細を見る | |
キュレル キュレル 潤浸保湿 スキンリペアUVセラム | 2,200円 |
| 日焼け止め・UVケアランキング第30位 | テクスチャは、驚くほど軽やか。 ほんのりベージュ色で、肌にのせると とろりとよく伸び密着する感覚です | 詳細を見る | |
サンカット® サンカットR パーフェクトUV エッセンス |
| 日焼け止め・UVケアランキング第33位 | テクスチャーはかなり伸びがいいので全身に広げやすく使いやすい! | 詳細を見る | ||
ニベア ニベアUV ディープ プロテクト&ケア エッセンス | 1,078円 |
| 日焼け止め・UVケアランキング第56位 | 塗るとさらっとぴたっと肌に密着し日焼け止め効果あるのにパリパリせずしっとり🥺✨ | 詳細を見る | |
キュレル 潤浸保湿 UVエッセンス | 1,760円 |
| 日焼け止め・UVケアランキング第46位 | みずみずしいテクスチャー。 伸びが良く、肌馴染みが良い使い心地✨ | 詳細を見る | |
ビオレ ビオレUV アクアリッチ アクアプロテクトローション(水層パック) | 1,078円 |
| 日焼け止め・UVケアランキング第47位 | まるで水のようなさらさらのテクスチャーで塗り広げたら素早く肌に馴染んで密着してくれます👏 | 詳細を見る | |
ビオレ UV アスリズム スキンプロテクトエッセンス | オープン価格 |
| 日焼け止め・UVケアランキング第55位 | ウォーターベースなのでさらっとスルスルお肌に塗れる。保湿成分で肌の乾燥を防ぐ! | 詳細を見る |
ぽみち🕊さんの人気クチコミ
「ジェル膜が固まる」ってどんなもんよ😏😏 と思ったら まじで色もツヤも落ちなくて😳😳 ヌーディカラーは色定着しないの多いから 唇の色濃い族としてはうれし😍 今日買ったけど明日別カラー買い足したいww
もっと見る
467
83
- 2022.03.10
着けるとハチワレとちいかわはほぼ見えない💦 流れ星は白塗りだからはっきり見えてハイライト効果⭐ もっとハチワレちゃん見えて欲しかったかもー! 気づいてくれたら相当うれしいやつ
もっと見る
353
49
- 2023.12.22
全30色のうち持ってる5色🫶🏻 リップにもチークにも使えてふわっとブラーな質感がかんわいいのよ🥺 ND02 ND03あたりだとリップに使うとわたしには白すぎた チークに使うとちょうどよし! 蓋の色、中身の見た目、塗った色がそれぞれ違うんだよね🤔! 大きい韓国のオリーブヤングにも5色しか置いてなくて、全色見てみたいなぁ!!!🫶🏻
もっと見る
274
110
- 2024.03.15
マット3色+グリッター2色+シマー1色に 少しラメ入りのチークが付いた これだけで統一感のある全顔メイクができるパレット💘 ヌードベージュ系パレットの中では ローズカラーやピンク色のグリッターも入ってて 甘めな構成♥ 締め色のマットブラウンは眉もできるから 本当に全顔メイクできる! ナチュラルだけど 大人っぽくもあるメイクができるよ🥰
もっと見る
228
37
- 2022.09.10
ピールって名前だけどピーリングのような皮を剥くものではなくて角質をケアしてターンオーバーを整える美容液💖 私は皮膚薄めなのでピーリング系は避けてて、これも評判良いのは知りつつ名前で避けてた けど使ってみて、もっと早く使えばよかったー😭💖ってなった! とろみはなくて、香りも微かな保湿剤っぽい香り以外はほぼ無臭だから"使ってる感"がないなーと思ったけど 連日使うと肌が滑らかになってる感じがした! 大富豪なら全身に使いたいぐらいの実感…!💖 ターンオーバーが整うのは肌トラブルの予防にもなるから使い続けたいな💖
もっと見る
227
21
- 2022.07.24
グロスのようなテクスチャで濡れツヤすぎてぷるツヤ♡ まぶた、頬、デコルテにジューシーなツヤを足せる♥ まぶた全体に使うと二重幅に溜まるから目頭と眉毛の間の凹んでる部分に使うと目の立体感が出てかわいいよ💖
もっと見る
226
47
- 2022.05.29
商品詳細情報VELY VELY ビタミントーンアップサンセラム
- ブランド名
- VELY VELY(ブリーブリー)
- ランキングIN
- 全体ランキング年代別ランキング肌質別ランキング
- 容量・参考価格
- 30ml: 3,025円
- 商品説明
- 肌ケアとサンケアを同時に叶えるサンセラム登場。 グレープフルーツ*成分で肌へビタミン補給とトーンアップを実現。 トーンアップ効果があるため、メイクアップ下地にも使用できます。 *グレープフルーツ果実水
- メーカー名
- BUGUNFNC CO., LTD
- 発売日
- 2021/6/23
- カテゴリ
- ベースメイク > 日焼け止め・UVケア > 日焼け止めローション
- 成分
- <30ml> グレープフルーツ果実水、アジピン酸ジブチル、水、BG、安息香酸アルキル(C12-15)、パラメトキシケイヒ酸イソアミル、イソペンチルジオール、トリ(カプリル酸/カプリン酸)グリセリル、ジエチルアミノヒドロキシベンゾイル安息香酸ヘキシル、リンゴ酸ジイソステアリル、ビスエチルヘキシルオキシフェノールメトキシフェニルトリアジン、テレフタリリデンジカンフルスルホン酸、酸化チタン、ナイアシンアミド、トロメタミン、水添ポリオレフィン(C6-20)、1,2-ヘキサンジオール、ヒドロキシアセトフェノン、(アクリレーツ/アクリル酸アルキル(C10-30))クロスポリマー、ドロメトリゾールトリシロキサン、ポリヒドロキシステアリン酸、(HDI/トリメチロールヘキシルラクトン)クロスポリマー、香料、リモネン、リナロール、クエン酸、エチルヘキシルグリセリン、ラウリン酸ポリグリセリル-10、プロパンジオール、アルミナ、トリエトキシカプリリルシラン、アデノシン、酸化鉄、トマトカルス培養エキス、アボカド油脂肪酸ブチル、ホホバ種子油、スクワラン、トマト果実エキス、トコフェロール、ビサボロール、フラーレン、加水分解ヒアルロン酸、マルトデキストリン、キシリチルグルコシド、無水キシリトール、キシリトール、グルコース、クエン酸Na、シアノコバラミン
![LIPS[リップス] - コスメのクチコミ検索アプリ](https://cdn.lipscosme.com/assets/lips_logo_full_2022-bc7b4bc9dd66035bc5696b0d16bc3d38a7be357186656c039e68cc4cf21ae675.png)

コメント